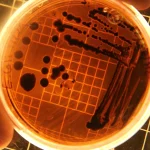

Расте бројот на жртвите од масакрот во Грац – засега 9 мртви и десеттина повредени
Масакрот во средното училиште во Грац, Австрија, е дело на ученик во училиштето, кој сметал дека бил злоставуван, тврдат австриски медиуми, откако беше објавена веста дека најмалку осум лица се мртви по пукотницата што се случила утрово во училиште во округот Ленд.
Австриските медиуми објавуваат дека дека напаѓачот испукал куршуми во две училници. Меѓу жртвите имало и наставници и ученици. Според веродостојни извори, во моментот 9 лица се мртви, од кои 2 биле девојчиња во петто одделение.
Осомничениот сторител бил пронајден мртов во еден од тоалетите. Според медиумите, тој се самоубил.
Бројот на жртви продолжува да расте. Бројот на сериозно повредени е двоцифрен.
Неколку стотици полицајци моментално се на местото на настанот, вклучувајќи ги и членовите на единицата „Кобра“.
-
Latest news
Tags
Џо Бајден Владимир Путин Володимир Зеленски Извадок на дел од дневните настани Илон Маск Ковачевски. Пендаровски ТА Турист Битола Туристичка Агенција - Турист Битола бајден војна германија доналд трамп извадок киев кина нато новак ѓоковиќ одземеното вратено на сопственикот османи приведен дилер приведено едно лице пронајдена дрога северна кореја сончево турција
ЗА НАС
ОhridSky е ваш доверлив извор за сеопфатно и избалансирано покривање на вестите. Со посветеност на интегритет и точност, обезбедуваме длабинско известување кое ги открива приказните што се најважни.
Links

© 2025 OhridSky. Сите права задржани.